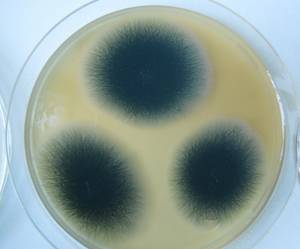
MSU_FS-02526 01, Район Ша Тай (Sa Thầy district), Kon Tum province (Vietnam)

Total items: 1
Total pages: 1
Organisms
- Specimen ID
- 0000000905514
- Species
- Brevistachys subsimplex
- Strain
- MSU_FS-02526
- Place of isolation
- Район Ша Тай (Sa Thầy district), Kon Tum province (Vietnam)
- Placename
- Ро Кой (Rơ Kơi commune)
- Synonyms
- Stachybotrys subsimplex